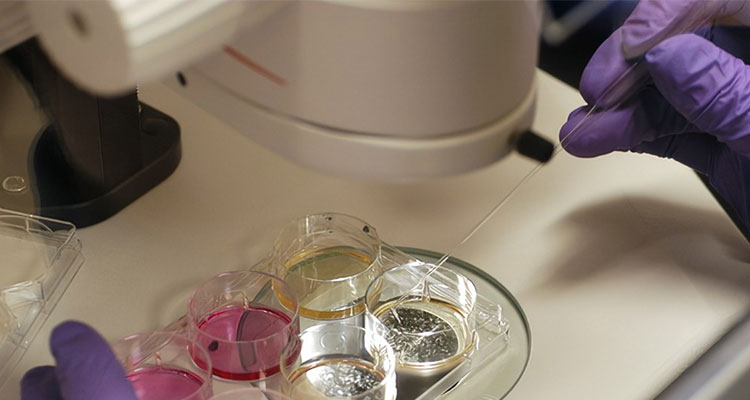

-
更新時(shí)間:2023-01-12制藥需要凈化、無(wú)塵車間,車間新建工藝復(fù)雜、潔凈級(jí)別和無(wú)菌的要求也較高。其裝修也大有講究。...
-
更新時(shí)間:2023-01-12醫(yī)院的空氣潔凈是以控制細(xì)菌濃度為*終目標(biāo)的所有措施中一項(xiàng)必要的、有較高保障性的措施...
-
更新時(shí)間:2023-01-11醫(yī)院機(jī)構(gòu)內(nèi)窺中心通風(fēng)空調(diào)設(shè)計(jì)...
-
更新時(shí)間:2023-01-09新建二代測(cè)序?qū)嶒?yàn)室部分參考標(biāo)準(zhǔn)...
-
更新時(shí)間:2023-01-09細(xì)胞實(shí)驗(yàn)室的常規(guī)區(qū)域分布設(shè)計(jì)...
-
更新時(shí)間:2023-01-09新建細(xì)胞實(shí)驗(yàn)室溫濕度、潔凈度相關(guān)環(huán)境要求...
-
更新時(shí)間:2023-01-05整體定制化實(shí)驗(yàn)臺(tái)...
-
更新時(shí)間:2023-01-04磁共振室工程設(shè)計(jì)九大注意事項(xiàng)...
-
更新時(shí)間:2023-01-03病理科在建筑布局上劃分為病理實(shí)驗(yàn)區(qū)、辦公管理里區(qū)...
-
更新時(shí)間:2023-01-03嚴(yán)格按照現(xiàn)代化實(shí)驗(yàn)室建設(shè)思路規(guī)劃設(shè)計(jì)充分利用好現(xiàn)有空間發(fā)揮*大作用,符合人體工程學(xué);安全、健康、節(jié)能、環(huán)保、人性化、智能化、靈活多變綜合考慮,達(dá)到安全可靠經(jīng)久耐用...